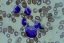
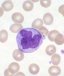

|
Гематологический отдел занимается консультациями и лечением
как стационарных, так и амбулаторных больных с острыми и хроническими заболеваниями
крови. Отделение занимается широким спектром болезней, включая острую и
хроническую лейкемию, миелому, амилоидоз, злокачественные опухоли костного
мозга, нарушения, ведущие к панцитопении, идиопатической тромбоцитопенической
пурпуре (ITP), тромбоцитопенической пурпуре (TTP), аденопатии и другим
анемиям, включая анемию доброкачественного течения; гемостатическими и
когуляционными нарушениями, ведущими как к кровотечениям так и к тромбозу,
артериальной и венозной тромбоэмболией и гиперсвёртываемостью крови. Для
амбулаторных больных производится химиотерапия и переливание крови. |

|
